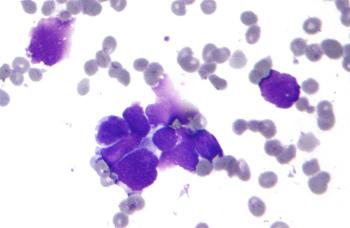
Стадии рака влагалища

Международная классификация рака влагалища по стадиям

Стадии рака влагалища — основной показатель, предопределяющий тактику лечения и его прогнозы. Поэтому диагностика в заграничных клиниках организована таким образом, чтобы специалисты могли получить полную информацию о заболевании и разработать эффективную программу постадийного лечения.
Содержание:
- Международная классификация рака влагалища по стадиям
- Клиническая картина рака влагалища по стадиям
- Методики диагностики рака влагалища по стадиям
- Методики лечения рака влагалища по стадиям
- Профилактика рака влагалища
- Прогнозы при вагинальном раке
Международная классификация рака влагалища по стадиям
Онкологи всего мира, в том числе и специалисты, работающие в ведущем онкологическом центре Москвы ОАО Медицина, пользуются международной классификацией вагинального рака по стадиям (система TNM).
Т — означает первичное новообразование:
Тх — на основании имеющейся информации невозможно оценить наличие патологии;
Тх — на основании имеющейся информации невозможно оценить наличие патологии;- Т0 — отсутствие первичного новообразования;
- Тis — выявление преинвазивной карциномы;
- Т1 — локализованная раковая опухоль (находится в пределах влагалища);
- Т2 — поражение паравагинальных тканей, тазовые стенки при этом не поражаются;
- Т3 — поражение тазовых стенок;
- Т4 — поражение слизистой мочевого пузыря, также в опухолевый процесс может быть вовлечена прямая кишка, новообразование выходит за границы таза и распространяет метастазы.
N — означает поражение регионарных лимфоузлов (тазовых, паховобедренных):
- Nх — имеющаяся информация не позволяет оценить регионарные лимфоузлы;
- N0 — отсутствие метастатических поражений;
- N1 — метастатическое поражение регионарных лимфоузлов.
М — означает отсутствие или наличие отдаленных метастазов:
- Мх — имеющаяся информация не позволяет выявить отдаленные метастатические очаги;
- М0 — метастатические поражения отсутствуют;
- М1 — обнаружение отдаленного метастазирования.
Лечение рака влагалища за границей сопровождается не только классификацией опухоли по стадиям, но и гистопатологической дифференцировкой, которая обозначается как G:
- GX — невозможно определить степень дифференцировки;
- G1 — дифференцировка высокой степени;
- G2 — средней степени;
- G3 — низкой степени;
- G4 — опухоль не подлежит дифференцировке.
Клиническая картина рака влагалища по стадиям
На этапе, когда развитие патологии только начинается, клиническая картина, как правило, не проявляется. На первой стадии могут присутствовать незначительные изменения, которым женщины обычно не придают значения. И это становится основной причиной того, что лечение рака влагалища в Израиле или в другой стране начинается слишком поздно и не позволяет сохранить фертильность пациенток.
С развитием патологии до второй стадии могут появиться выделения белого цвета, иногда с запахом гнили, кровотечения, как беспричинные, так и вызванные контактом с опухолевой поверхностью. Также на этой стадии уже присутствуют боли. Несмотря на достаточную выраженность признаков, и на этом этапе многие женщины не спешат посещать доктора.
Симптомы, возникающие на третьей стадии, сложно игнорировать, но при этом стоит отметить их схожесть с другими болезнями женской репродуктивной системы:
 постоянно присутствующая боль, которая объясняется поражением соседних тканей и нервов;
постоянно присутствующая боль, которая объясняется поражением соседних тканей и нервов;- появление кровотечений между менструациями, у женщин в постменопаузе такие выделения возникают спонтанно (в этом возрасте любые вагинальные выделения крови являются патологическими и требуют немедленного обращения в клинику);
- появление вагинальных выделений, как при молочнице;
- сложности с мочеиспусканием и опорожнением кишечника.
Эти признаки свидетельствуют о серьезных поражениях органов, расположенных в малом тазу. Последняя стадия заболевания сопровождается усугублением уже имеющихся признаков и появлением симптомов метастазирования:
- патологические вагинальные выделения;
- постоянные боли внизу живота и в крестце;
- учащенные позывы к опорожнению мочевого пузыря;
- запоры;
- резкое снижение веса;
- постоянное ощущение усталости и слабости;
- отечность нижних конечностей.
Насколько эффективной будет борьба с заболеванием, зависит о своевременности обращения в клинику, прохождения обследования и начала терапии. Пациенты, которые хотят получить высококачественные услуги, но не имеют возможности выехать за рубеж, могут пройти лечение рака влагалища в Москве. Клиника Медицина работает по мировым стандартам, применяет передовые методики лечения и реабилитации.
Методики диагностики рака влагалища по стадиям
Стадийность заболевания учитывается не только при лечении патологии, но и на этапе ее выявления. Сначала назначаются стандартные обследования, а после обнаружения опухоли пациентку направляют на углубленное обследование.
Ранние стадии заболевания выявляются с помощью:
- гинекологического осмотра;
- мазка по Папаниколау (ПАП-тест);
- биопсии, после которой проводится лабораторное исследование биоматериала для определения его гистологической и цитологической структуры.
На поздних стадиях требуется применение современных визуализационных аппаратов для досконального изучения ракового образования, поэтому, кроме осмотра, пальпации лимфоузлов и биопсии, проводятся:
- иммунологическое исследование флоры влагалища;
- бактериальное исследование флоры влагалища;
- ректороманоскопия;
- цистоскопия;
- ультразвуковое исследование (органы малого таза, лимфоузлы, печень, почки);
- рентгенография радиоизотопная;
- экстреторная урография;
- лимфография;
- диагностическое выскабливание;
- оценивается состояние яичников и матки.
Если выясняется, что опухоль запущена до последней стадии, то дополнительно проводятся КТ и МРТ. После этого тщательно изучаются все результаты диагностики, и составляется тактика лечения. Стоит отметить, что при желании лечиться за границей, можно выбрать клиники, услуги которых будут незначительно отличаться в большую сторону от расценок частных онкоклиник Москвы. Примером является стоимость лечения в Израиле.
Методики лечения рака влагалища по стадиям
 Если женщина обращается в клинику на нулевой стадии, то патология сводится к миниинвазивному удалению очага поражения с сохранением прилегающих тканей — применяется лазерная хирургия. В зависимости от характера развития опухоли может быть назначена брахитерапия, химиотерапия.
Если женщина обращается в клинику на нулевой стадии, то патология сводится к миниинвазивному удалению очага поражения с сохранением прилегающих тканей — применяется лазерная хирургия. В зависимости от характера развития опухоли может быть назначена брахитерапия, химиотерапия.
На первой стадии применяется дистанционное и внутреннее радиолечение. Проводится операция вагинэктомия — местная резекция опухоли с последующей радиотерапией. Удаляется опухоль и лимфоузлы, после чего удаленные ткани отправляются в лабораторию на исследование. После операции также проводится радиотерапия. Если опухоль распространилась на матку, то этот орган тоже подлежит удалению.
Программа лечения второй стадии может включать радиотерапию как самостоятельную методику, а также в сочетании с вагинэктомией (облучение назначается после операции).
На третьей стадии тоже назначается радиолечение, которое дополняется химиотерапией. Для достижения лучшего результата методики лечения комбинируются, в программу лечения входит операция, радиотерапия и лучевая терапия.
На четвертой стадии применяется аналогичная тактика лечения, при этом масштабы операции определяются степенью распространения новообразования. Химиотерапия и радиотерапия могут применяться в качестве симптоматического лечения, которое приводит к улучшению качества жизни и увеличивает ее продолжительность, купирует метастатический процесс.
Лечение рака в Москве, которое выбирают многие пациентки из России, позволяет добиться высоких результатов. Лечение проходит по персональным протоколам, с подбором наиболее эффективных, передовых методик.
Профилактика рака влагалища
Во избежание развития этой опасной болезни необходимо соблюдать основные правила профилактики:
- ежедневная интимная гигиена;
- своевременная терапия инфекционных заболеваний и воспалительных процессов;
- прохождение регулярных осмотров у гинеколога (2 раза в год);
- использование барьерной контрацепции и планирование беременности;
- отказ от курения, умеренное употребление алкоголя.
Несмотря на огромные возможности медицины в области диагностики и лечения рака, случаи развития злокачественных опухолей влагалища выявляются с каждым годом все чаще. Каждая женщина может самостоятельно снизить риски развития рака, если будет следить за здоровьем и соблюдать рекомендованный график профилактических посещений доктора.
Прогнозы при вагинальном раке
Лечение ранних стадий рака сопровождается благоприятными прогнозами и возможностью сохранить целостность репродуктивных органов. Исход лечения поздних стадий заболевания зависит от того, насколько сильно поражены прилегающие и отдаленные органы, лимфатические узлы.
Средние показатели пятилетней выживаемости на 1 стадии 75-95%, на 2 стадии — до 80%, на 3 стадии — до 55%, на 4 стадии — до 25%.







